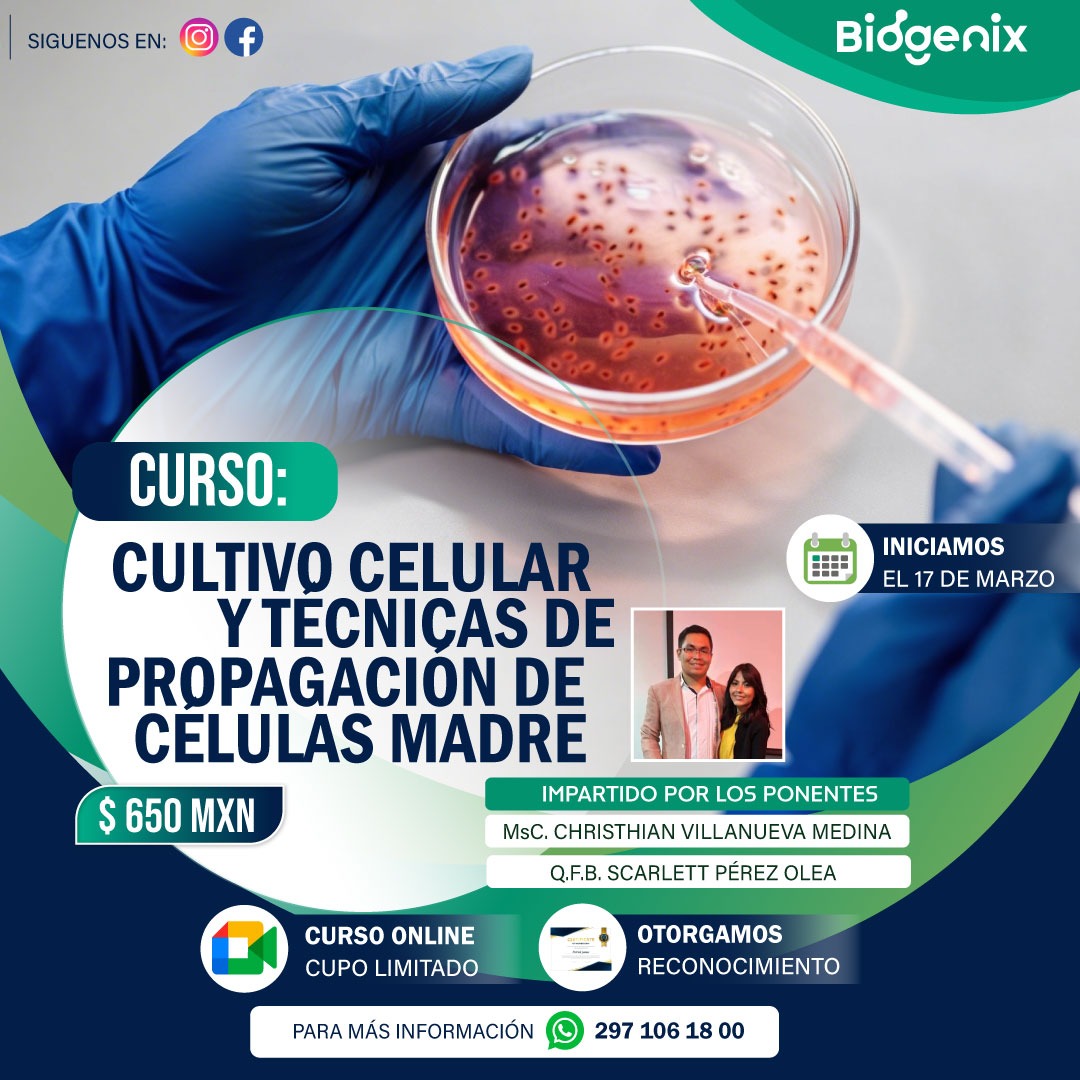
Cultivo Celular
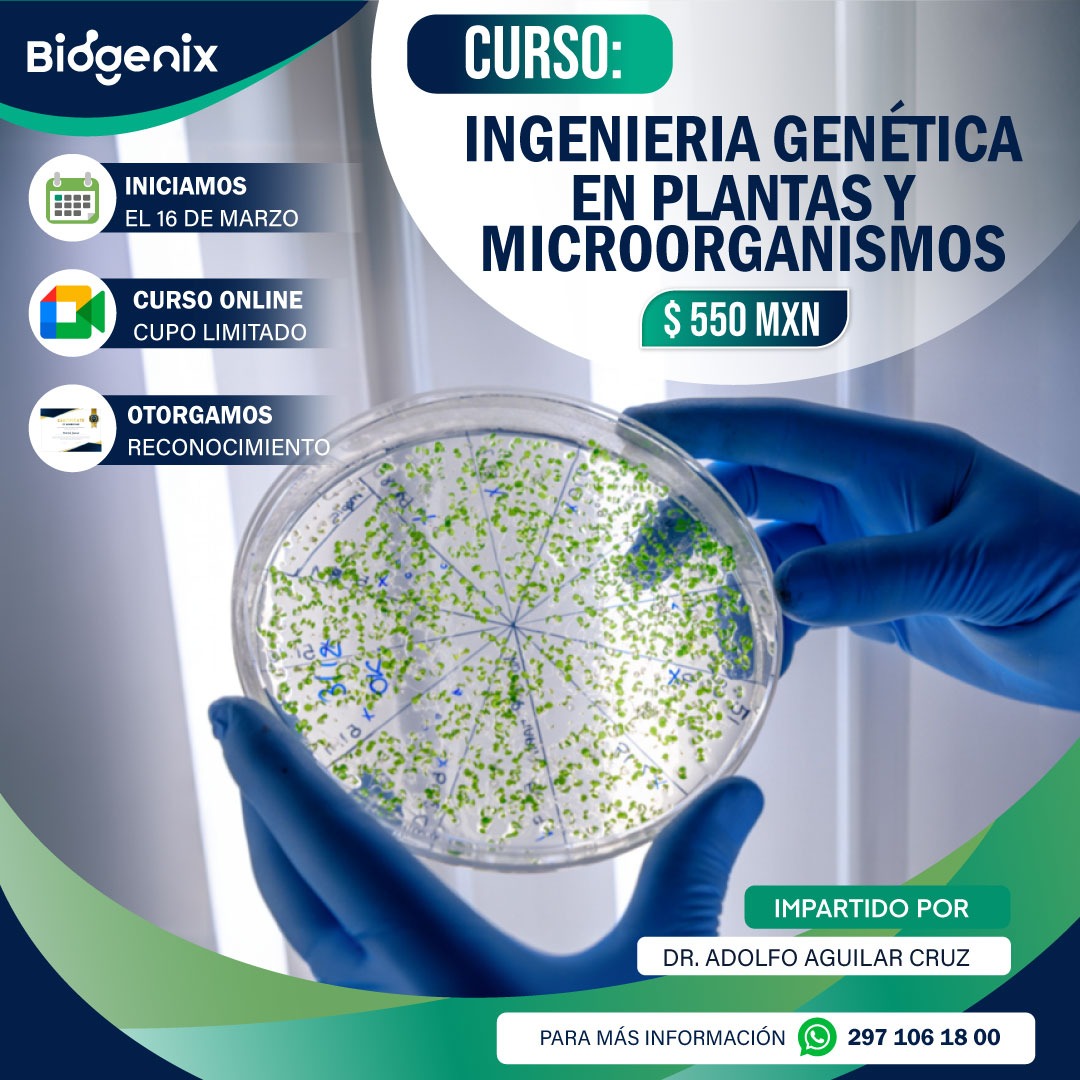
Genética Molecular

0
Alumnos
En Biogenix impulsamos soluciones educativas para quienes buscan crecer en salud, agricultura y medio ambiente con una experiencia clara, actual y especializada.
Alumnos
Cursos Online
Modalidad Online
En Biogenix, creemos en el poder de la Biotecnología para transformar la ciencia y convertirla en soluciones innovadoras para los sectores de la salud, la agricultura y el medio ambiente.
Nuestro enfoque se centra en la aplicación práctica de la biotecnología para abordar los retos más urgentes, mejorando la calidad de vida y contribuyendo al bienestar global.
¡Únete a nosotros y sé parte del cambio! 🌍💚










Todos nuestros cursos se imparten en modalidad online e incluyen certificado con valor curricular, QR escaneable y folio de respaldo. Da clic en inscribirme y te redirigimos por WhatsApp.

Aprende herramientas para interpretar datos biotecnológicos y tomar decisiones basadas en evidencia.
Conoce principios, técnicas y aplicaciones del trabajo con células en laboratorio.

Explora el papel de los microorganismos y su aplicación en ciencia, salud y procesos productivos.

Descubre alternativas sostenibles y el potencial biotecnológico de nuevos materiales biodegradables.
Fortalece tus bases en genética aplicada y su utilidad dentro de la biotecnología moderna.

Conoce el diseño y aplicación de herramientas biotecnológicas para detección y monitoreo.
Una muestra visual del estilo, presencia y crecimiento de nuestra comunidad.




La confianza de nuestros alumnos refleja el compromiso y la calidad de cada capacitación.






Escríbenos por WhatsApp y recibe atención personalizada sobre cursos, certificación y próximos programas.